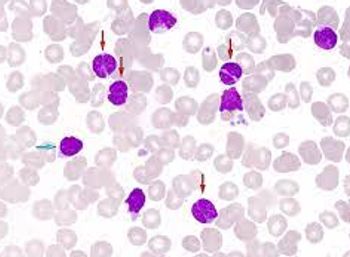

Using biomarkers to guide treatment decisions are increasingly being leveraged across various cancers, and metastatic colorectal cancer (mCRC) is no exception. However, the positivity rates of these biomarkers can differ across different patient characteristics, according to a recent study.